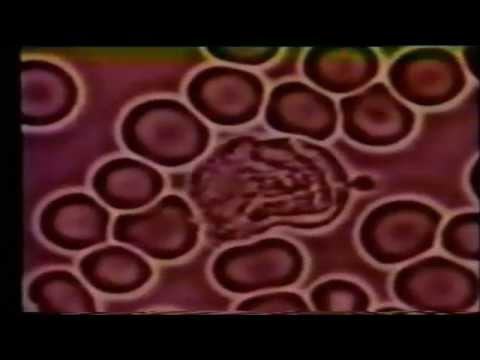

Galerijas
-
 1 video 1. apr 2021 09:55eksperimentu
1 video 1. apr 2021 09:55eksperimentu -
1 video31. mar 2021 10:44tīrīšanā
1 video31. mar 2021 10:44tīrīšanā -
 2 video21. mar 2021 00:35Ditta rīko
2 video21. mar 2021 00:35Ditta rīko -
 1 video18. mar 2021 19:28kultūra bez cietumiem
1 video18. mar 2021 19:28kultūra bez cietumiem -
 1 video17. mar 2021 10:06Latvieti brauc mājās
1 video17. mar 2021 10:06Latvieti brauc mājās -
 1 video13. mar 2021 08:22gorilla zin
1 video13. mar 2021 08:22gorilla zin -
 2 video 8. mar 2021 14:44gnostic-kontrole
2 video 8. mar 2021 14:44gnostic-kontrole -
 2 video 3. mar 2021 09:46anonīmie laupa cilvēk karan…
2 video 3. mar 2021 09:46anonīmie laupa cilvēk karan… -
 1 video24. feb 2021 09:53zombie inžjekcijas?
1 video24. feb 2021 09:53zombie inžjekcijas? -
 1 video21. feb 2021 13:00WDA ārsti atmasko Cv melu m…
1 video21. feb 2021 13:00WDA ārsti atmasko Cv melu m… -
 1 attēlsmorgellons cv testos
1 attēlsmorgellons cv testos
19. feb 2021 19:11 -
 4 attēlitesti vai ēģiptes inkvizīci…
4 attēlitesti vai ēģiptes inkvizīci…
13. feb 2021 13:16 -
 2 video 6. feb 2021 12:54atkāpies tumsas trīsvienība
2 video 6. feb 2021 12:54atkāpies tumsas trīsvienība -
 1 video 3. feb 2021 22:48armijā
1 video 3. feb 2021 22:48armijā -
 1 video 2. feb 2021 09:05pašmīlā
1 video 2. feb 2021 09:05pašmīlā -
 1 video 1. feb 2021 21:18gaisma
1 video 1. feb 2021 21:18gaisma




